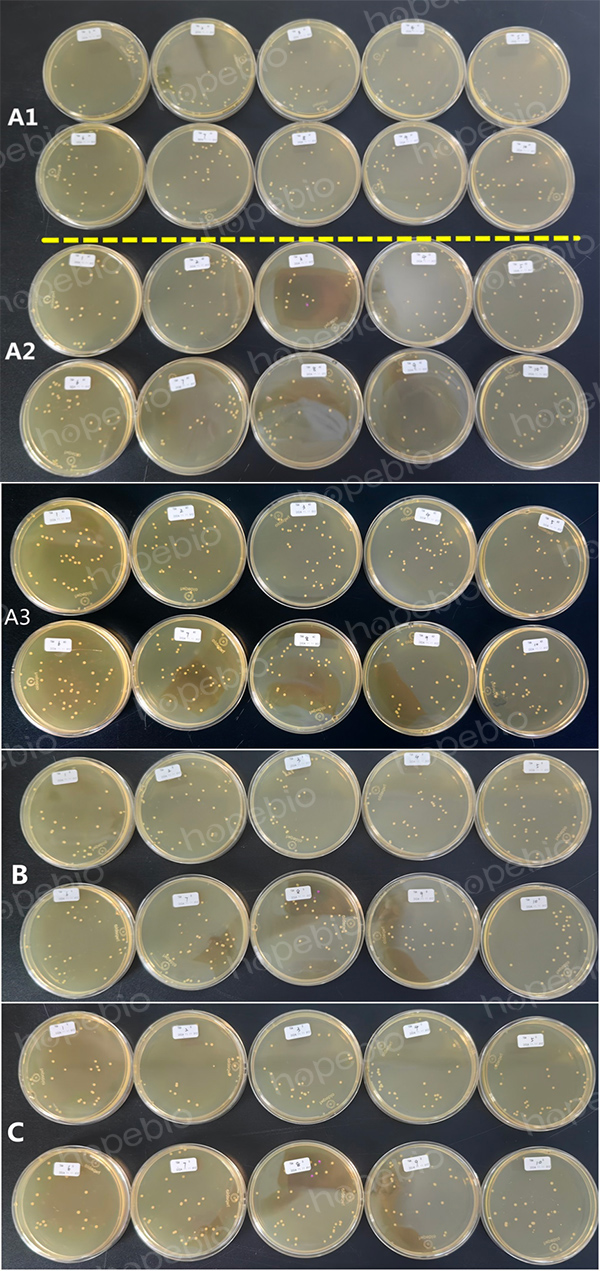

海博微信公众号
海博微信公众号
 海博天猫旗舰店
海博天猫旗舰店


 海博微信公众号
海博微信公众号
 海博天猫旗舰店
海博天猫旗舰店




一、简述
对于样品中的微生物计数测定,通常采用两种方法,涂布法和倾注法。“涂布”最初是一个工业用语,是为了防腐、绝缘、装饰等目的,以液体或粉末形式在织物,纸张,金属箔或板等物体表面上涂盖薄层的操作。
在微生物计数接种时,借鉴了这种说法,简单说就是将含有微生物的样品液,滴加于培养基平板上,迅速用涂布棒在表面作来回左右的涂抹,让菌液均匀扩散分布,培养后就可长出单个的微生物的菌落。具体操作方法可参考:涂布平板法。
对于涂布的工具——涂布棒,目前市面上有各种涂布棒,从材质上看有不锈钢的、玻璃的、塑料的,从形状上分有三角形、L行、T型,大小粗细各种各样(图1)。有关涂布棒的制作方式可参考:一种简易好用的涂布棒制作方法。

图1 各种各样的涂布棒
(从左到右依次为:不锈钢、玻璃、塑料)
不同的涂布棒对涂布计数的结果有没有影响?是不是每涂一个板,必须要更换涂布棒?本文着重以具体试验的形式具体说明,以期为广大实验操作人员提供借鉴。
二、试验设置
分别采用三种涂布棒共设5组试验,每组各设10个培养基平板,滴加相同浓度相同体积的菌液,A1、A2、A3所用涂布棒为采血管自制,B涂布棒为玻璃棒制作,C涂布棒为一次性塑料成品,每组具体操作时,A1组10个板,共用一个涂布棒,A2组每涂一个板更换一个涂布棒,A3组不用涂布棒,将菌液分散到平板上,倾斜摊匀即可;B组使用玻璃棒,每两个平板更换一个涂布棒;C组10个板共用一个涂布棒。
表1 试验方案设置表
|
组别 |
涂布棒更换方式 |
|
|
A(采血管自制) |
A1 |
不更换 |
|
A2 |
每板更换一个 |
|
|
A3 |
不用涂布棒,直接滴匀 |
|
|
B(玻璃棒制作) |
每两板换一个 |
|
|
C(塑料成品) |
不更换 |
|
三、试验结果及分析
从表2、图2看出,A1、A2、B、C平均数均为28CFU-29CFU,各组间无明显差别,A3平均数最高,且有菌数最高值37,由此可以判断,不用涂布棒的情况下,测定的菌数最能反应样品中的菌数真实值,如果能够明确把握每100μL样品中的菌数小于200CFU,可以不用涂布棒,采用直接滴匀的方式进行接种;涂布棒的材质、大小和更换频率,对测得的菌数多少无明显影响,只要能保证菌液涂匀即可。
表2 不同涂布方案的计数结果
|
组别 |
重复及平板编号 |
平均 |
|||||||||
|
1 |
2 |
3 |
4 |
5 |
6 |
7 |
8 |
9 |
10 |
||
|
A1 |
27 |
31 |
30 |
26 |
25 |
29 |
30 |
30 |
27 |
28 |
28.3 |
|
A2 |
27 |
34 |
19 |
33 |
33 |
36 |
29 |
28 |
23 |
28 |
29 |
|
A3 |
37 |
32 |
34 |
29 |
24 |
34 |
34 |
33 |
27 |
28 |
31.2 |
|
B |
24 |
36 |
25 |
31 |
35 |
27 |
32 |
33 |
26 |
25 |
29.4 |
|
C |
29 |
26 |
29 |
35 |
31 |
20 |
32 |
33 |
29 |
20 |
28.4 |
图2 不同试验方案的计数结果
四、结论与讨论
(1)不用涂布棒的情况下,测定的菌数最能反应样品中的菌数真实值,可能的情况下,应首选这种方式进行接菌;
(2)如果样品中菌数比较多,为了防止涂布不均匀,尽量使用涂布棒进行涂布,涂布棒的材质、大小和更换频率,对测得的菌数多少无明显影响,只要能保证将菌液涂匀即可;
(3)每个稀释度至少用一个涂布棒,更换稀释度时需更换不同的涂布棒,在由低浓度向高浓度涂抹时,也可以不更换涂布棒。【1】
五、注意事项
(1)滴加菌液前,要将平板在无菌环境下吹风干燥,去除平板表面的水分;
(2)涂布时,用涂布棒将菌液自平板中央均匀向四周涂布扩散,切忌用力过猛将菌液直接推向平板边缘或将培养基划破;
(3)涂布时要保持手法的稳定性和一致性,涂布速度要适中,避免过快导致微生物分布不均或过慢导致培养基干燥;
(4)重复实验是确保实验结果准确性的重要手段。通过在同一稀释度下涂布多个平板并统计菌落数的平均值,能够减小实验误差并提高数据可靠性。在重复实验中,如果某个平板的菌落数与其他平板相差较大,说明可能存在操作失误,这时应该舍弃该数据,并找出原因进行修正。
参考文献:
【1】张敬慧,郭云霞主编.酿酒微生物 第2版[M].中国轻工业出版社.2021:321.
注:本文属海博生物原创,未经允许不得转载。
上一篇:最基础的平板划线 最漂亮的三区 努力划出尽量多的单菌落!
下一篇:琼脂含量对动力试验结果的影响
| 相关文章: | ||



